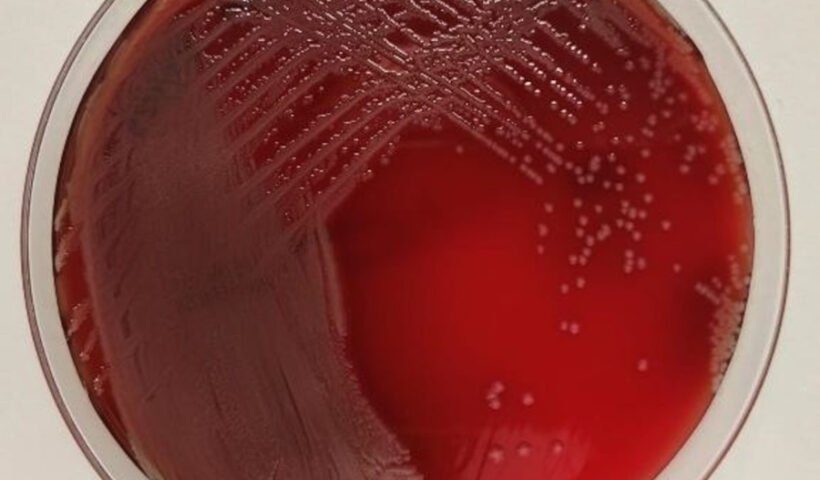
P.aeruginosa (Isabel M Barceló)

Las benzodiacepinas se utilizan para sedar a pacientes conectados a un respirador. No obstante, la ventilación mecánica aumenta drásticamente el riesgo de sufrir neumonía. ¿Podrían estos fármacos actuar sobre las bacterias causantes de infección, facilitando que causen la enfermedad? Una investigación con la bacteria P. aeruginosa describe cómo, en presencia de benzodiacepinas, este patógeno pasa de ser altamente agresivo a optar por un estilo de vida más pacífico o “silencioso”, diseminándose sin ser detectado, hasta que ya es demasiado tarde para evitar la infección.
Las benzodiacepinas podrían facilitar la infección en pacientes ventilados alterando el comportamiento bacteriano